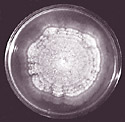

Dutch elm disease
Ophiostoma species (originally Ophiostoma ulmi and now mainly Ophiostoma novo-ulmi in North America and Europe)
Elm (Ulmus species)
 |
 |
| Dutch elm disease owes its name to the fact that its cause was first identified in the Netherlands in 1921. Since then, the disease has been found in much of Europe and North America, and in parts of Asia. The disease affects many species of elm, but the American elm (Ulmus americana), shown in these photos, is particularly susceptible. |
Symptoms and Signs
Dutch elm disease is a vascular wilt disease. The earliest external symptoms of infection are often yellowing and wilting (flagging) of leaves on individual branches (Figure 3). These leaves often turn brown and curl up as the branches die, and eventually the leaves may drop off. Although initially only a part of the tree crown may be affected, symptoms may progress rapidly throughout the crown. Highly susceptible trees often die in a single year, but others may linger for several years. Symptoms progress quickly and death may occur rapidly in trees infected in early spring, while trees infected later in the summer may survive longer.
 |
 |
| Figure 3 |
Figure 4 |
If the bark of infected elm twigs or branches is peeled back, brown discoloration is seen in the outer layer of wood. This discoloration in the xylem actually occurs before the foliar symptoms described above are seen; foliar symptoms result when sap flow ceases in the infected wood. Xylem browning is often discontinuous. In cross section, it appears as a circle of brown dots or a ring (Figure 4). Other wilt diseases of elm, such as Verticillium wilt, also cause sapwood discoloration, so positive diagnosis of Dutch elm disease depends on laboratory culturing and identification of the fungus.
The signs (fungal structures) of the Dutch elm disease pathogens are found within infected elm trees, and are described in the Pathogen Biology section.
Pathogen Biology
The Ophiostoma species that cause Dutch elm disease grow and reproduce only within elms. At times they are parasites, feeding on living tissue of the elm tree; at other times they are saprophytes, getting nourishment from dead elm tissue. Ophiostoma ulmi caused the original Dutch elm disease epidemic in Europe and North America in the mid-1900s. Ophiostoma novo-ulmi, an even more aggressive pathogen of elms, largely replaced O. ulmi during the second half of the 20th century. These fungi spread within stems and roots of living elms both by passive transport of spores and by mycelial growth of colonies initiated by spores that germinate in the xylem. The mycelium of these fungi is creamy white (Figure 5) and is composed of septate hyphae with haploid nuclei.
Figure 5 |
Asexual reproduction
Ophiostoma ulmi and O. novo-ulmi have two asexual forms that produce asexual spores called conidia. In the xylem vessels of living elm trees, small, white, oval conidia (Figure 6) are formed in clusters on short mycelial branches. These conidia are carried in the xylem vessels where they reproduce by budding, germinate to produce mycelium, and thus spread the disease throughout the tree.
 |
 |
| Figure 6 |
Figure 7 |
In dying or recently dead trees, conidia (Figure 7) are produced by mycelium growing in the bark and in tunnels created by beetles just under the bark. These sticky conidia are produced at the tips of 1-2 mm tall synnemata. Each synnema consists of hyphae fused to form an erect, dark stalk with a round, nearly colorless head of sticky spores. Beetle vectors carry the sticky spores to new elm trees.
Sexual reproduction
Based on the structures produced by their sexual stage, the Dutch elm disease pathogens are placed in the ascomycete genus Ophiostoma. When two mating types come in contact, ascospores are produced in spherical, black, long-necked perithecia (Figure 8). Perithecia form in the bark, either singly or in groups. Ascospores are produced in asci that degenerate inside of the perithecia. The free ascospores are discharged at the opening of the perithecial neck where they accumulate in sticky droplets that may be disseminated by beetle vectors.

Figure 8 |
Disease Cycle and Epidemiology
Disease cycle
The Dutch elm disease pathogens overwinter in the bark and outer wood of dying or recently dead elm trees and in elm logs as mycelia and synnemata with conidia. The fungi are spread from these sites by their vectors - elm bark beetles (Figure 9). Two beetle species spread the pathogens in North America: the smaller European elm bark beetle (Scolytus multistriatus) and the native elm bark beetle (Hylurgopinus rufipes). The adult female beetle bores through the bark of dead or dying elm trees and elm logs and creates a tunnel in the wood as she feeds. She lays eggs in the tunnel behind her. The eggs hatch into larvae (Figure 10) that begin to feed, creating tunnels at right angles to the maternal tunnel.
 |
 |
| Figure 9 |
Figure 10 |
The resulting pattern of tunnels is called a gallery (Figure 11). The larvae pupate and emerge through the bark as adults (Figure 12). If the fungi are present in the tree or log, the emerging adults carry thousands of sticky conidia on their bodies.
 |
 |
| Figure 11 |
Figure 12 |
Newly-emerged S. multistriatus adults feed in the twig crotches of elm branches (Figure 13); newly emerged H. rufipes adults tunnel in the bark of elm branches and trunks. As the beetles feed, fungal spores are deposited. The beetle vectors only feed on healthy elms for a few days. Then they fly to dying or recently dead elm trees or to freshly cut elm wood to feed, create galleries, and lay eggs.
The spores dislodged from elm bark beetles in feeding wounds and tunnels germinate and produce mycelium that grows into the xylem. The mycelium produces millions of small, white, oval conidia that spread through the xylem sap.
 |
 |
| Figure 13 |
Figure 14 |
The fungi also produce enzymes and probably toxins that degrade plant cell walls and kill xylem parenchyma cells. In addition, the fungi induce hormonal imbalance that leads to the formation of tyloses (Figure 14), overgrowths of parenchyma cells that push into and block the water-conducting xylem cells. The blockage of the xylem by tyloses and gums (thought to be products of plant cell wall breakdown) causes one of the diagnostic symptoms of Dutch elm disease, wilting of leaves. The killing of xylem parenchyma cells causes another diagnostic symptom, brown discoloration just under the bark.
Epidemiology
Infections that take place in the spring or early summer involve “springwood” which has very long xylem vessels. In these vessels the fungi can spread rapidly throughout the tree, which then may die quickly. Later in the season, the fungi are restricted to the much shorter vessels of the “summerwood,” and the fungi spread much more slowly in the tree. Localized infections often result, and the tree is likely to survive longer.

Figure 15 |
Healthy elm trees can become infected by the feeding of spore-contaminated elm bark beetles or through the development of grafts between their roots and the roots of infected trees (Figure 15). Trees infected via beetle vectors often first develop symptoms in an upper section of the crown, whereas trees infected via root grafts often first develop symptoms lower in the crown. When the fungi are introduced through a root graft, they can be quickly distributed throughout the tree in the vascular system, and the entire tree may soon wilt and die. Root grafts form naturally between closely spaced elm trees with intertwined roots. Large elms growing within 7 meters (20 feet) of each other have almost 100% chance of becoming infected through root grafts. The likelihood of spread is lower when the elms are at least 13 meters (40 feet) apart.
The severity and rate of spread of Dutch elm disease depend on the species of the pathogen, how rapidly the elm bark beetles reproduce, the level of susceptibility of the elm hosts, and the environment. Temperatures around 20°C (68°F) favor the formation of conidia, whereas perithecia are induced at temperatures of 8-10°C (46-50°F).
In the absence of effective disease management, Dutch elm disease increases exponentially until an affected elm population is greatly depleted. Seedlings and many saplings escape and live long enough to reproduce, so even the most susceptible elm species have never been threatened with extinction by Dutch elm disease. Wild elm populations in the eastern and Midwestern U.S. have increased in recent decades, and this increase has led to renewed prominence of Dutch elm disease in landscapes.
Dutch Elm Management
Cultural strategies
Today, some communities maintain active programs to manage Dutch elm disease because they have found that it is cheaper to manage the disease than to remove the large dead trees that it leaves behind. Some communities focus on cultural practices for disease management, including the avoidance of monocultures of elm trees, the removal of all dying or recently dead branches, trees, and cut wood (sanitation), and the breakage of root grafts between adjacent elms. To be successful, diligent inspection of all elm trees in an area several times each growing season is required. Wood must be burned, chipped or buried so that it cannot provide a home for beetle vectors (Figure 16).

Figure 16 |
Organized community sanitation programs can delay the loss of elms. It has been estimated that the time when half of the elm trees in an area have been lost can be delayed by between 7 and 30 years. If privately owned trees are included in a program of inspection and mandatory removal, the longer end of this range is more likely. At best, this is a delaying tactic in the battle against Dutch elm disease.
Chemical strategies
In the past, insecticides were sprayed on elm trees in attempts to kill the beetle vectors of Dutch elm disease (Figure 17). This management strategy was expensive, not very effective, and came under attack from people concerned about the impact of insecticide use on wildlife and people.
 |
 |
 |
| Figure 17 |
Figure 18 |
Figure 19 |
More recently, fungicides have been injected into trees infected by or at risk of infection by the Dutch elm disease pathogens (Figure 18). These systemic chemicals are most effective if they are used to prevent new infections or to prevent the movement of the fungi into parts of a tree that are not yet colonized. Several different fungicides have been used, but all are relatively expensive, and none is completely effective. For these reasons, chemical management of Dutch elm disease is commonly used only to protect elm trees of high value, such as those along the Mall in Washington, D.C. (Figure 19) or large trees in the yards of well-maintained properties.
Breeding for resistance
The long-term solution to Dutch elm disease lies in the development of disease-resistant cultivars of elms. Several Asian elm species have moderate to high resistance, and breeding programs in both Europe and the U.S. have introduced resistance from these species into native elm species (Figure 20). Other programs have focused on identifying and cloning individual American elm specimens that have moderate resistance to Dutch elm disease. The American elm breeders also would like to maintain the elegant vase shape of the American elm - the quality that made it a highly desirable shade tree. As a result of decades of efforts by elm breeders, several hybrid and clonal elms are now available that have very good resistance to Dutch elm disease (Figure 21).
 |
 |
| Figure 20 |
Figure 21 |
Historical Significance
The first North American Dutch elm disease epidemic began when Ophiostoma ulmi was introduced in the 1920s by furniture makers who used imported European elm logs to make veneer for cabinets and tables. Some of the beetle vectors of the Dutch elm disease pathogens also were brought here from Europe, years before the fungi were introduced. When the more aggressive pathogen, O. novo-ulmi, was later introduced in North America, it killed many elms that had survived the original epidemic. Dutch elm disease epidemics that resulted from movement of Ophiostoma species between and across continents vividly illustrate the dangers inherent in our movement of plant material around the world.
A Dutch scientist, Marie Beatrice Schwarz, is credited with first identifying the causal agent of what was to become known as Dutch elm disease. Another Dutch scientist, Christine Johanna Buisman, who had seen the disease in her homeland, first identified Dutch elm disease in Ohio in 1930. The disease spread up and down the U.S. East Coast and west across the continent, reaching the West Coast in 1973. Over 40 million American elm trees have been killed by this disease, and today it is still a very destructive disease of shade trees in the U.S.
Many of the elm trees in North America and Europe were planted in rows along streets and walkways, or in hedgerows, or on dikes. The elm trees made effective windbreaks (Figure 22), and the large, overarching branches created beautiful shady canopies (Figure 23). These dense plantings of elm trees are examples of monocultures.
 |
 |
| Figure 22 |
Figure 23 |
Monocultures are created when plants of the same species are grown in close proximity, with few other types of plants present. People have planted monocultures for hundreds of years and there are many reasons why monocultures are desirable. Monocultures provide uniformity, which is desirable both for aesthetic reasons and for production practices. Planting, management, and harvest are all simpler when one kind of plant is grown in an area.
Dangers, however, are inherent in monocultures. Because all of the plants in a monoculture are very much alike, they are all subject to the same catastrophic problems. A disease, insect or weather condition that harms one plant is likely to harm them all. Monoculture is the main reason why Dutch elm disease has been so devastating in our towns and cities. The pathogens can move between closely spaced trees via insect vectors or root grafts, leaving devastation in their wake (Figure 24). The Dutch elm disease epidemics illustrate the value of diversity in plant populations.

Figure 24 |
Selected References
Ash, C.L., ed. 2001. Shade Tree Wilt Diseases. American Phytopathological Society, St. Paul. MN.
Brasier, C.M. 1991. Ophiostoma novo-ulmi sp. nov., causative agent of current Dutch elm disease pandemics. Mycopathologia 115:151-161.
D’Arcy, C.J. and D.M. Eastburn. Dutch elm disease. Plants, Pathogens, and People. http://www.ppp.uiuc.edu
Dunn, C.P., ed. 2000. The Elms: Breeding, Conservation, and Disease Management. Kluwer Academic, Boston, Dordrecht.
Holmes, F.W. and H.M. Heybroek. 1990. Dutch Elm Disease - The Early Papers. APS Press, St. Paul, MN.
National Public Radio program: Dutch elm disease. An interview with Mark Stennes, plant pathologist from Top Notch Treecare, who explains the current situation with Dutch elm disease in Minneapolis/St. Paul, MN and answers call-in questions from listeners. This file is available as a download from APSnet.
Sinclair, W.A. and H.H. Lyon. 2005. Diseases of Trees and Shrubs, 2nd ed. Cornell University Press, Ithaca, NY.
Smalley, E.B. and R.P. Guries. 1993. Breeding elms for resistance to Dutch elm disease. Annual Review of Phytopathology 31:325-352.
Townsend, A.M. and L.W. Douglass. 2004. Evaluation of elm clones for tolerance to Dutch elm disease. Journal of Arboriculture 30:179-183.
Wolkomir, R. 1998. Racing to revive our embattled elms. Smithsonian 29(3):40-49.
